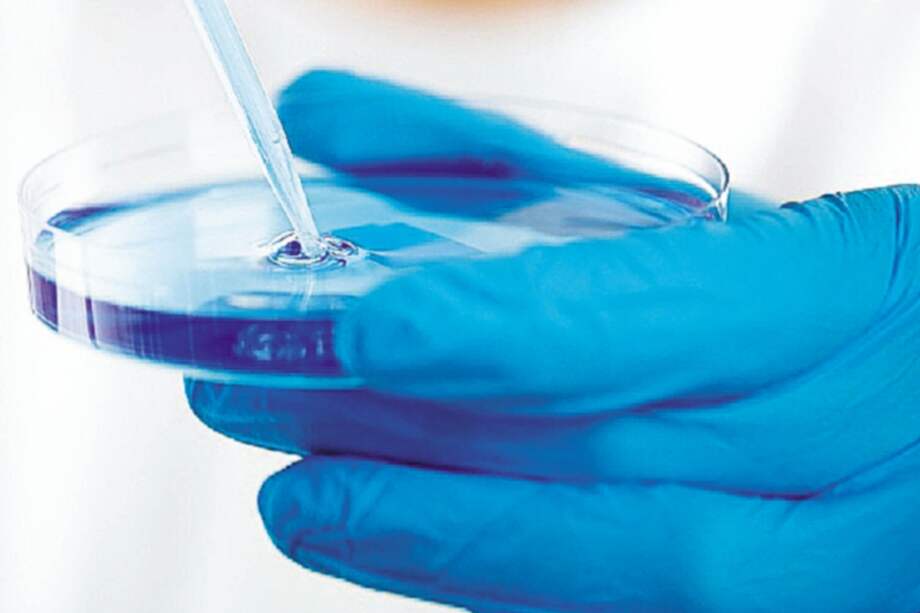
Todo el Senado votó a favor de la creación del Ministerio de Ciencia.

Escucha este artículo
Audio generado con IA de Google
0:00
/
0:00
De acuerdo con el proyecto de ley, el nuevo ministerio “será el encargado de formular, orientar, dirigir, coordinar, ejecutar, implementar y controlar la política del Estado en materia” de ciencia. Puntualmente, la nueva cartera deberá crear un Plan Nacional de Ciencia, Tecnología e Innovación, que incluya estos tres principios en la política económica y social del país.
Además, entre sus funciones está “fortalecer el Sistema Nacional de Ciencia, Tecnología e Innovación (SNCTI) y fortalecer una cultura basada en la generación, apropiación y divulgación del conocimiento y la investigación científica”. En ese sentido, explicó el senador, el nuevo organismo no implica la disolución de Colciencias, sino la integración de este a la nueva cartera.
Aunque aún no hay claridad sobre los detalles de cómo se hará esa integración, Nancy Patricia Gutiérrez, ministra del Interior, aclaró que la idea “no es generar más burocracia”, sino elevar las funciones de Colciencias al nivel de un ministerio.
Tampoco se ha definido cuántos recursos serán asignados a la cartera, ni cómo se hará su gestión, teniendo en cuenta que hoy todo el dinero para ciencia en el país es administrado por Colciencias.
El proyecto de ley fue acompañado desde el principio por la Academia Colombiana de Ciencias Exactas, Físicas y Naturales, que, en enero de este año, generó un documento llamado “Manifiesto de la Ciencia”, en el que 31 científicos de todo el país de diversas disciplinas hicieron un diagnóstico de la ciencia en el país y propusieron soluciones para impulsarla.
Una de sus principales críticas era la falta “de un verdadero sistema y de una política nacional de ciencia, tecnología e innovación (CTI) que incluya a todos los actores y establezca mecanismos de coherencia entre la política educativa, la industrial, y la de ciencia y tecnología”.
Tras la sanción presidencial, el Gobierno de Iván Duque tiene un año para hacer realidad el andamiaje sobre el cual echará a andar el nuevo ministerio.
Colombia es uno de los pocos países de América Latina que no contaba con un ministerio de ciencia ni una entidad con
ese nivel dentro de la estructura estatal.